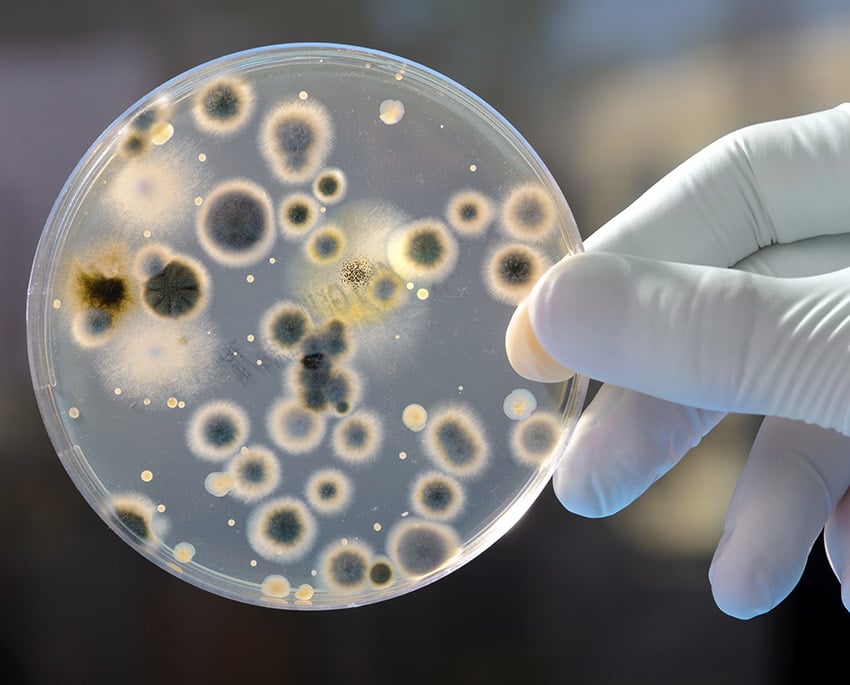
Stachybotrys är en mögelart som kallas svartmögel/svarta prickar

Lever i kolonier
Här kan man t.ex. nämna Stachybotrys, som är en mögelart som kallas svartmögel/svarta prickar. Det finns de mögelarterna som inte är farliga – däremot är det inte optimalt att ha det i sitt hem.
Även vitmögel och rödmögel bör nämnas här då de också kan ha ovälkomna effekter för fastigheten och hälsan.
Mögelsvamp lever av/på organiska material i kolonier som hyfer, eller tunna förgrenade filament, som i sin tur bildar svampens mycelium.
Fukt och rätt tillväxtvillkor gör att mögelsvamparnas sporer kan spira så att nya mycel skapas. Små mycel fragment som släpps ut i luften blir också till nya kolonier, och på så sätt sprider möglet sig.
Svartmögel orsakar hälsoproblem
En av alla dessa olika mögel typerna som inte bör underskattas är svartmögel. Som tidigare nämnt visar svartmögel sig med mörk/svart färg oftast i form av prickar och har en tendens att bildas på ställen som är svåra för oss att se och inspektera.
Det växer oftast på mörka ställen där luften är trängd och fuktig som i vrår, i källaren eller andra gömställen. Detta gör att denna typ av svamp spridning är mer vanlig än vad man befarar.
Mögelsvamparna utsöndrar bland annat svampgifter, mykotoxiner, som de använder mot konkurrenter i närmiljön. Svamparna utsöndrar också olika enzymer som kan bryta ner de material som svamp kolonierna lever på.

Kan orsaka allergiliknande symptom
Däremot är det inte bara material de bryter ner utan människor och djur kan också få in svamp gifterna genom inandning eller via intag av föda och dryck, vilket i sin tur kan orsaka olika hälsoproblem. Man kan exempelvis få allergiliknande symptom, såsom rinnande ögon och näsa, huvudvärk, trötthet, andningsbesvär och utslag. I värsta fall orsakar svartmögel cancer.
Människor som lider av astma kan uppleva att mögelsvamp förvärrar symptomen, och man misstänker också att mögel kan vara en direkt orsak till kroniska allergier och astma.
Hösnuva kan också orsakas av allergi mot mögelsvampens sporer, och ger samma symptom som allergi mot exempelvis gräs, björk eller hassel.
Kan även synas tydligt
Denna mögelart visar sig inte bara på ställen som är svåra att inspektera utan kan även synas tydligt på utsidan av fasaden, insidan av huset, i badrummet eller på andra ställen. Så fort man upptäcker detta eller har minsta lilla misstanke om att det kan vara svartmögel bör man beställa ett mögeltest för att avgöra om det är just den sorten eller något annat.
Många av dessa mögelarter är väldigt lika i utseende och är lätta att blanda ihop. Därmed är det väsentligt att ta dit en expert som får kika på det om man känner sig osäker.

Formerar sig som växt pollen
Mögelsporer kan skapa ny tillväxt och påminner därför om växtfrön, även om de sprider sig på samma sätt som pollen, helst i torrt och blåsigt väder. Mögelsvamparnas sporer finns i luften utomhus i mängder som växlar efter de olika årstiderna.
På så sätt påminner de om pollen, eftersom mängden sporer ökar under våren, är störst runt midsommar och sedan avtar. Under vintern när det är kallt finns det mycket få sporer i luften eller inga alls, eftersom svamparna trivs bäst när det är fuktigt och varmt.
Varför är det viktigt att bekämpa mögelsvamp?
Det finns många olika orsaker, främst ur ett hälsoperspektiv men även bostaden du lever i. Tar man inte tag i ett sådant problem kommer svartmöglet förstöra den ytan den växer på och det vill ingen.
Efter att du har beställt ett mögeltest hos oss och får svar på vilken typ av svampbildning du har hemma är det viktigt att du bekämpar den med omedelbar verkan. Hittar du farlig mögelbildning i din bostad i god tid kan du oftast bekämpa problemet själv med olika tillvägagångssätt. Skulle det däremot upptäckas i ett senare skede och orsakat mer skada får man ta hjälp av en saneringsfirma eller liknande.







